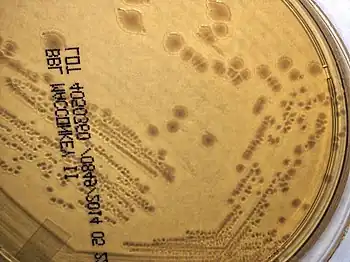

Virulence factor

Virulence factors are cellular structures, molecules and regulatory systems that enable microbial pathogens (bacteria, viruses, fungi, and protozoa) to achieve the following:[1][2]
- Colonization of a niche in the host (this includes movement towards and attachment to host cells)[1][3]
- Immunoevasion, evasion of the host's immune response[1][3][4]
- Immunosuppression, inhibition of the host's immune response (this includes leukocidin-mediated cell death)[1]
- Entry into and exit out of cells (if the pathogen is an intracellular one)[5]
- Obtain nutrition from the host[1]
Specific pathogens possess a wide array of virulence factors. Some are chromosomally encoded and intrinsic to the bacteria, whereas others are obtained from mobile genetic elements like plasmids and bacteriophages. Virulence factors encoded on mobile genetic elements spread through horizontal gene transfer, and can convert harmless bacteria into dangerous pathogens. Bacteria like Escherichia coli O157:H7 gain the majority of their virulence from mobile genetic elements. Gram-negative bacteria secrete a variety of virulence factors at host-pathogen interface, via membrane vesicle trafficking as bacterial outer membrane vesicles for invasion, nutrition and other cell-cell communications. It has been found that many pathogens have converged on similar virulence factors to battle against eukaryotic host defenses. These obtained bacterial virulence factors have different routes used to help them survive and grow: factors are used to assist and promote colonization of the host. These factors include adhesins, invasins, and antiphagocytic factors.Additionally factors, including toxins, hemolysins and proteases, bring damage to the host.[6][7][8]
Attachment, immunoevasion, and immunosuppression

Bacteria produce various adhesins including trimeric autotransporter adhesins and a wide variety of other surface proteins to attach to host tissue. [9][10]
Capsules, made of carbohydrate, form part of the outer structure of many bacterial cells including Neisseria meningitidis. Capsules play important roles in immune evasion, as they inhibit phagocytosis, as well as protecting the bacteria while outside the host.[11][12]
Another group of virulence factors possessed by bacteria are immunoglobulin (Ig) proteases, immunoglobulins are antibodies expressed and secreted by hosts in response to an infection. These immunoglobulins play a major role in destruction of the pathogen through mechanisms such as opsonization. Some bacteria, such as Streptococcus pyogenes, are able to break down the host's immunoglobulins using proteases.[13][14]
Viruses also have notable virulence factors. Experimental research, for example, often focuses on creating environments that isolate and identify the role of "niche-specific virulence genes". These are genes that perform specific tasks within specific tissues/places at specific times; the sum total of niche-specific genes is the virus' virulence. Genes characteristic of this concept are those that control latency in some viruses like herpes. Murine gamma herpesvirus 68 (γHV68) and human herpesviruses depend on a subset of genes that allow them to maintain a chronic infection by reactivating when specific environmental conditions are met. Even though they are not essential for lytic phases of the virus, these latency genes are important for promoting chronic infection and continued replication within infected individuals.[15]
Enzymes
Some bacteria, such as Streptococcus pyogenes, Staphylococcus aureus and Pseudomonas aeruginosa, produce a variety of enzymes which cause damage to host tissues. Enzymes include hyaluronidase, which breaks down the connective tissue component hyaluronic acid; a range of proteases and lipases; DNases, which break down DNA, and hemolysins which break down a variety of host cells, including red blood cells.[16][17][18][19]
GTPases

A major group of virulence factors are proteins that can control the activation levels of GTPases. There are two ways in which they act. One is by acting as a GEF or GAP, and proceeding to look like a normally eukaryotic cellular protein. The other is covalently modifying the GTPase itself. The first way is reversible; many bacteria like Salmonella have two proteins to turn the GTPases on and off. The other process is irreversible, using toxins to completely change the target GTPase and shut down or override gene expression.[20][21]
One example of a bacterial virulence factor acting like a eukaryotic protein is Salmonella protein SopE it acts as a GEF, turning the GTPase on to create more GTP. It does not modify anything, but overdrives normal cellular internalization process, making it easier for the bacteria to be colonized within a host cell.[22][23]
YopT (Yersinia outer protein T) from Yersinia is an example of modification of the host. It modifies the proteolytic cleavage of carboxyl terminus of RhoA, releasing RhoA from the membrane. The mislocalization of RhoA causes downstream effectors to not work.[24][25]
Toxins
A major category of virulence factors are bacterial toxins. These are divided into two groups: endotoxins and exotoxins.[5]
Endotoxins
Endotoxin is a component, lipopolysaccharide (LPS) of the cell wall of gram-negative bacteria. It is the lipid A part of this LPS which is toxic.[5] Lipid A is an endotoxin. Endotoxins trigger intense inflammation. They bind to receptors on monocytes causing the release of inflammatory mediators which induce degranulation. As part of this immune response cytokines are released; these can cause the fever and other symptoms seen during disease. If a high amount of LPS is present then septic shock may result which, in severe cases, can lead to death. As glycolipids , endotoxins are not bound by B or T-cell receptors .[3][26][27]
Exotoxins
Exotoxins are actively secreted by some bacteria and have a wide range of effects including inhibition of certain biochemical pathways in the host. The two most potent known exotoxins[5] are the tetanus toxin (tetanospasmin) secreted by Clostridium tetani and the botulinum toxin secreted by Clostridium botulinum.
Exotoxins are also produced by a range of other bacteria including Escherichia coli; Vibrio cholerae (causative agent of cholera) and Clostridium difficile (causative agent of pseudomembranous colitis).[28][29] [30]A potent three-protein virulence factor produced by Bacillus anthracis, called anthrax toxin, plays a key role in anthrax pathogenesis. Exotoxins are extremely immunogenic meaning that they trigger the humoral response.[31][3]
Exotoxins are also produced by some fungi as a competitive resource. The toxins, named mycotoxins, deter other organisms from consuming the food colonised by the fungi. As with bacterial toxins, there is a wide array of fungal toxins. Arguably one of the more dangerous mycotoxins is aflatoxin produced by certain species of the genus Aspergillus (notably A. flavus). If ingested repeatedly, this toxin can cause serious liver damage.[32][33][34]
-
Endotoxin(lipopolysaccharide) -
Tetanus Toxin Heavy Chain C Fragment(Exotoxin)
Various virulence factors
Examples of virulence factors for Staphylococcus aureus are hyaluronidase, protease, coagulase, lipases, deoxyribonucleases and enterotoxins. Examples for Streptococcus pyogenes are M protein, lipoteichoic acid, hyaluronic acid capsule, destructive enzymes (including streptokinase, streptodornase, and hyaluronidase), and exotoxins (including streptolysin). Examples for Listeria monocytogenes include internalin A, internalin B, listeriolysin O, and actA, all of which are used to help colonize the host. Examples for Yersinia pestis are an altered form of lipopolysaccharide, type three secretion system, and YopE and YopJ pathogenicity. The cytolytic peptide Candidalysin is produced during hyphal formation by Candida albicans; it is an example of a virulence factor from a fungus. Other virulence factors include factors required for biofilm formation and integrins . [35]
Research
Strategies to target virulence factors and the genes encoding them have been proposed.[36] Small molecules being investigated for their ability to inhibit virulence factors and virulence factor expression include alkaloids,[37] flavonoids,[38] and peptides.[39]
Experimental studies are done to characterize specific bacterial pathogens and to identify their specific virulence factors. Virulence factors can be better understood via identification and analysis of the infectious process in hopes that new diagnostic techniques, specific antimicrobial compounds, and effective vaccines or toxoids may be eventually produced to treat and prevent infection. There are three general experimental ways for the virulence factors to be identified: biochemically, immunologically, and genetically. For the most part, the genetic approach is the most extensive way in identifying the bacterial virulence factors. Bacterial DNA can be altered from pathogenic to non-pathogenic, random mutations may be introduced to their genome, specific genes encoding for membrane or secretory products may be identified and mutated, and genes that regulate virulence genes maybe identified.[40][41][7]
Experiments involving Yersinia pseudotuberculosis have been used to change the virulence phenotype of non-pathogenic bacteria to pathogenic. Because of horizontal gene transfer, it is possible to transfer the clone of the DNA from Yersinia to a non-pathogenic E. coli and have them express the pathogenic virulence factor. Transposon, a DNA element inserted at random, mutagenesis of bacteria DNA is also a highly used experimental technique done by scientists. These transposons carry a marker that can be identified within the DNA. When placed at random, the transposon may be placed next to a virulence factor or placed in the middle of a virulence factor gene, which stops the expression of the virulence factor.[42][43][44]
See also
- Resistance-Nodulation-Cell Division Superfamily (RND)
- Filamentation
References
- ↑ 1.0 1.1 1.2 1.3 1.4 Casadevall A, Pirofski LA (2009). "Virulence factors and their mechanisms of action: the view from a damage –response framework". Journal of Water and Health. 7 (Supplement 1): S2 – S18. doi:10.2166/wh.2009.036. PMID 19717929.
- ↑ Hill, Colin (November 2012). "Virulence or Niche Factors: What's in a Name?". Journal of Bacteriology. 194 (21): 5725–5727. doi:10.1128/JB.00980-12. Archived from the original on 6 March 2023. Retrieved 6 March 2023.
- ↑ 3.0 3.1 3.2 3.3 Cavaillon, Jean-Marc (July 2018). "Exotoxins and endotoxins: Inducers of inflammatory cytokines". Toxicon: Official Journal of the International Society on Toxinology. 149: 45–53. doi:10.1016/j.toxicon.2017.10.016. ISSN 1879-3150. Archived from the original on 28 August 2022. Retrieved 3 March 2023.
- ↑ Cross, Alan S (2008). "What is a virulence factor?". Critical Care. 12 (6): 197. doi:10.1186/cc7127. PMC 2646308. PMID 19090973.
{{cite journal}}: CS1 maint: unflagged free DOI (link) - ↑ 5.0 5.1 5.2 5.3 Levinson, W. (2010). Review of Medical Microbiology and Immunology (11th ed.). McGraw-Hill.
- ↑ Peterson, Johnny W. (1996). "Bacterial Pathogenesis". Medical Microbiology (4th ed.). University of Texas Medical Branch at Galveston. ISBN 978-0-9631172-1-2. Archived from the original on 2016-04-25. Retrieved 6 March 2023.
- ↑ 7.0 7.1 Sharma, Aditya Kumar; Dhasmana, Neha; Dubey, Neha; Kumar, Nishant; Gangwal, Aakriti; Gupta, Meetu; Singh, Yogendra (1 March 2017). "Bacterial Virulence Factors: Secreted for Survival". Indian Journal of Microbiology. 57 (1): 1–10. doi:10.1007/s12088-016-0625-1. PMID 28148975. Archived from the original on 30 November 2022. Retrieved 18 March 2023.
- ↑ LeBlanc, Jason J. (2003). "Implication of virulence factors in Escherichia coil O157:H7 pathogenesis". Critical Reviews in Microbiology. 29 (4): 277–296. doi:10.1080/713608014. ISSN 1040-841X. Archived from the original on 11 March 2023. Retrieved 11 March 2023.
- ↑ Kiessling, Andreas R.; Malik, Anchal; Goldman, Adrian (June 2020). "Recent advances in the understanding of trimeric autotransporter adhesins". Medical Microbiology and Immunology. 209 (3): 233–242. doi:10.1007/s00430-019-00652-3. ISSN 1432-1831. Archived from the original on 18 February 2023. Retrieved 4 March 2023.
- ↑ Klemm, Per; Schembri, Mark A. (1 March 2000). "Bacterial adhesins: function and structure". International Journal of Medical Microbiology. 290 (1): 27–35. doi:10.1016/S1438-4221(00)80102-2. ISSN 1438-4221. Retrieved 7 March 2023.
- ↑ Parker, Dane (6 October 2014). Bacterial Activation of Type I Interferons. Springer. ISBN 978-3-319-09498-4. Archived from the original on 4 March 2023. Retrieved 4 March 2023.
- ↑ Nguyen, Nixon; Ashong, Derrick (2022). "Neisseria Meningitidis". StatPearls. StatPearls Publishing. Archived from the original on 27 February 2023. Retrieved 12 March 2023.
- ↑ Mistry, Dippica; Stockley, Robert A. (January 2006). "IgA1 protease". The International Journal of Biochemistry & Cell Biology. 38 (8): 1244–1248. doi:10.1016/j.biocel.2005.10.005. Archived from the original on 18 February 2023. Retrieved 4 March 2023.
- ↑ Vega, Luis A.; Malke, Horst; McIver, Kevin S. (2022). "Virulence-Related Transcriptional Regulators of Streptococcus pyogenes". Streptococcus pyogenes: Basic Biology to Clinical Manifestations (2nd ed.). University of Oklahoma Health Sciences Center. Archived from the original on 11 March 2023. Retrieved 11 March 2023.
- ↑ Knipe, Howley, David, Peter (2013). Fields Virology, 6th Edition. Philadelphia, PA, USA: LIPPINCOTT WILLIAMS & WILKINS. p. 254. ISBN 978-1-4511-0563-6.
{{cite book}}: CS1 maint: multiple names: authors list (link) - ↑ Pancholi, Vijay; Caparon, Michael (2022). "Streptococcus pyogenes Metabolism". Streptococcus pyogenes: Basic Biology to Clinical Manifestations (2nd ed.). University of Oklahoma Health Sciences Center. Archived from the original on 3 March 2023. Retrieved 3 March 2023.
- ↑ Pancholi, Vijay; Chhatwal, Gursharan S. (1 January 2003). "Housekeeping enzymes as virulence factors for pathogens". International Journal of Medical Microbiology. 293 (6): 391–401. doi:10.1078/1438-4221-00283. ISSN 1438-4221. Retrieved 7 March 2023.
- ↑ Cheung, Gordon Y. C.; Bae, Justin S.; Otto, Michael (December 2021). "Pathogenicity and virulence of Staphylococcus aureus". Virulence. 12 (1): 547–569. doi:10.1080/21505594.2021.1878688. ISSN 2150-5608. Archived from the original on 18 January 2023. Retrieved 10 March 2023.
- ↑ Newman, J.; Floyd, R.; Fothergill, J. (2017). "The contribution of Pseudomonas aeruginosa virulence factors and host factors in the establishment of urinary tract infections". FEMS microbiology letters. Archived from the original on 10 March 2023. Retrieved 10 March 2023.
- ↑ Popoff, Michel R. (2014). "Bacterial factors exploit eukaryotic Rho GTPase signaling cascades to promote invasion and proliferation within their host". Small GTPases. 5: e28209. doi:10.4161/sgtp.28209. ISSN 2154-1256. Archived from the original on 2 August 2022. Retrieved 4 March 2023.
- ↑ Annous, Bassam; Gurtler, Joshua (18 July 2012). Salmonella: Distribution, Adaptation, Control Measures and Molecular Technologies. BoD – Books on Demand. p. 340. ISBN 978-953-51-0661-6. Archived from the original on 15 March 2023. Retrieved 15 March 2023.
- ↑ Nickerson, Cheryl A.; Schurr, Michael (28 November 2006). Molecular Paradigms of Infectious Disease: A Bacterial Perspective. Springer Science & Business Media. p. 258. ISBN 978-0-387-32901-7. Archived from the original on 8 March 2023. Retrieved 8 March 2023.
- ↑ Niu, Hua; Deng, Meihong (8 November 2022). The Role of Autophagy in Infectious Diseases. Frontiers Media SA. p. 178. ISBN 978-2-8325-0426-0. Archived from the original on 10 March 2023. Retrieved 10 March 2023.
- ↑ Boquet, Patrice; Lemichez, Emmanuel (1 May 2003). "Bacterial virulence factors targeting Rho GTPases: parasitism or symbiosis?". Trends in Cell Biology. 13 (5): 238–246. doi:10.1016/S0962-8924(03)00037-0. ISSN 0962-8924. Archived from the original on 13 March 2023. Retrieved 13 March 2023.
- ↑ Schmidt, Gudula (November 2011). "Yersinia enterocolitica outer protein T (YopT)". European Journal of Cell Biology. 90 (11): 955–958. doi:10.1016/j.ejcb.2010.12.005. ISSN 1618-1298. Archived from the original on 15 June 2022. Retrieved 5 March 2023.
- ↑ Das, A. P.; Kumar, P. S.; Swain, S. (15 January 2014). Recent advances in biosensor based endotoxin detection. pp. 62–75. Archived from the original on 17 June 2022. Retrieved 5 March 2023.
- ↑ Rietschel, Ernst T.; Kirikae, Teruo; Schade, F. Ulrich; Mamat, Uwe; Schmidt, Günter; Loppnow, Harald; Ulmer, Artur J.; Zähringer, Ulrich; Seydel, Ulrich; Di Padova, Franco; Schreier, Max; Brade, Helmut (February 1994). "Bacterial endotoxin: molecular relationships of structure to activity and function". The FASEB Journal. 8 (2): 217–225. doi:10.1096/fasebj.8.2.8119492. ISSN 0892-6638. Archived from the original on 17 August 2022. Retrieved 17 March 2023.
{{cite journal}}: CS1 maint: unflagged free DOI (link) - ↑ Welch, Rodney A. (June 2016). "Uropathogenic Escherichia coli-Associated Exotoxins". Microbiology Spectrum. 4 (3). doi:10.1128/microbiolspec.UTI-0011-2012. ISSN 2165-0497. Archived from the original on 15 June 2022. Retrieved 18 March 2023.
- ↑ Nair, G Balakrish; Narain, Jai P (2010). "From endotoxin to exotoxin: De's rich legacy to cholera". Bulletin of the World Health Organization. 88 (3): 237–240. doi:10.2471/BLT.09.072504. ISSN 0042-9686. Archived from the original on 8 April 2022. Retrieved 18 March 2023.
- ↑ Di Bella, Stefano; Ascenzi, Paolo; Siarakas, Steven; Petrosillo, Nicola; di Masi, Alessandra (3 May 2016). "Clostridium difficile Toxins A and B: Insights into Pathogenic Properties and Extraintestinal Effects". Toxins. 8 (5): 134. doi:10.3390/toxins8050134. ISSN 2072-6651. Archived from the original on 31 January 2023. Retrieved 18 March 2023.
{{cite journal}}: CS1 maint: unflagged free DOI (link) - ↑ Smith, H.; Keppie, J. (May 1954). "Observations on Experimental Anthrax: Demonstration of a Specific Lethal Factor produced in vivo by Bacillus anthracis". Nature. 173 (4410): 869–870. doi:10.1038/173869a0. ISSN 1476-4687. Archived from the original on 24 February 2023. Retrieved 14 March 2023.
- ↑ Rushing, Blake R.; Selim, Mustafa I. (February 2019). "Aflatoxin B1: A review on metabolism, toxicity, occurrence in food, occupational exposure, and detoxification methods". Food and Chemical Toxicology: An International Journal Published for the British Industrial Biological Research Association. 124: 81–100. doi:10.1016/j.fct.2018.11.047. ISSN 1873-6351. Archived from the original on 9 February 2023. Retrieved 8 March 2023.
- ↑ Hof, Herbert (March 2008). "Mycotoxins: pathogenicity factors or virulence factors?". Mycoses. 51 (2): 93–94. doi:10.1111/j.1439-0507.2007.01455.x. ISSN 0933-7407. Retrieved 9 March 2023.
- ↑ Magnussen, Arvin; Parsi, Mansour A (14 March 2013). "Aflatoxins, hepatocellular carcinoma and public health". World Journal of Gastroenterology : WJG. 19 (10): 1508–1512. doi:10.3748/wjg.v19.i10.1508. ISSN 1007-9327. Archived from the original on 4 July 2022. Retrieved 17 March 2023.
{{cite journal}}: CS1 maint: unflagged free DOI (link) - ↑ Bien, Justyna; Sokolova, Olga; Bozko, Przemyslaw (21 May 2018). "Characterization of Virulence Factors of Staphylococcus aureus: Novel Function of Known Virulence Factors That Are Implicated in Activation of Airway Epithelial Proinflammatory Response". Journal of Pathogens. 2011: 601905. doi:10.4061/2011/601905. PMC 3335658. PMID 22567334.
{{cite journal}}: CS1 maint: unflagged free DOI (link) - ↑ Keen, E. C. (December 2012). "Paradigms of pathogenesis: Targeting the mobile genetic elements of disease". Frontiers in Cellular and Infection Microbiology. 2: 161. doi:10.3389/fcimb.2012.00161. PMC 3522046. PMID 23248780.
- ↑ Deborah T. Hung; Elizabeth A. Shakhnovich; Emily Pierson; John J. Mekalanos (2005). "Small-molecule inhibitor of Vibrio cholerae virulence and intestinal colonization". Science. 310 (5748): 670–674. Bibcode:2005Sci...310..670H. doi:10.1126/science.1116739. PMID 16223984. S2CID 30557147.
- ↑ T.P. Tim Cushnie; Andrew J. Lamb (2011). "Recent advances in understanding the antibacterial properties of flavonoids". International Journal of Antimicrobial Agents. 38 (2): 99–107. doi:10.1016/j.ijantimicag.2011.02.014. PMID 21514796. Archived from the original on 2020-07-26. Retrieved 2022-06-16.
- ↑ Oscar Cirioni; Roberto Ghiselli; Daniele Minardi; Fiorenza Orlando; Federico Mocchegiani; Carmela Silvestri; Giovanni Muzzonigro; Vittorio Saba; Giorgio Scalise; Naomi Balaban & Andrea Giacometti (2007). "RNAIII-inhibiting peptide affects biofilm formation in a rat model of staphylococcal ureteral stent infection". Antimicrobial Agents and Chemotherapy. 51 (12): 4518–4520. doi:10.1128/AAC.00808-07. PMC 2167994. PMID 17875996.
- ↑ Wu, Hsing-Ju; Wang, Andrew H.-J.; Jennings, Michael P. (February 2008). "Discovery of virulence factors of pathogenic bacteria". Current Opinion in Chemical Biology. 12 (1): 93–101. doi:10.1016/j.cbpa.2008.01.023. ISSN 1367-5931. Archived from the original on 29 November 2022. Retrieved 8 March 2023.
- ↑ Johnson, J R (January 1991). "Virulence factors in Escherichia coli urinary tract infection". Clinical Microbiology Reviews. 4 (1): 80–128. doi:10.1128/cmr.4.1.80. ISSN 0893-8512. Retrieved 18 March 2023....review summarizes the virtual explosion of information regarding the epidemiology, biochemistry, mechanisms of action, and genetic basis of these urovirulence factors
- ↑ Brady, Mark F.; Yarrarapu, Siva Naga S.; Anjum, Fatima (2022). "Yersinia Pseudotuberculosis". StatPearls. StatPearls Publishing. Archived from the original on 15 June 2022. Retrieved 8 March 2023.
- ↑ Pushkareva, V. I.; Velichko, V. V.; Solokhina, L. V.; Litvin, V. Iu (2004). "[Variability of the clonal structure of Yersinia pseudotuberculosis population under different conditions]". Zhurnal Mikrobiologii, Epidemiologii I Immunobiologii (4): 31–35. ISSN 0372-9311. Archived from the original on 10 March 2023. Retrieved 10 March 2023.
- ↑ Bourque, Guillaume; Burns, Kathleen H.; Gehring, Mary; Gorbunova, Vera; Seluanov, Andrei; Hammell, Molly; Imbeault, Michaël; Izsvák, Zsuzsanna; Levin, Henry L.; Macfarlan, Todd S.; Mager, Dixie L.; Feschotte, Cédric (19 November 2018). "Ten things you should know about transposable elements". Genome Biology. 19: 199. doi:10.1186/s13059-018-1577-z. ISSN 1474-7596. Archived from the original on 5 October 2022. Retrieved 15 March 2023.
{{cite journal}}: CS1 maint: unflagged free DOI (link)